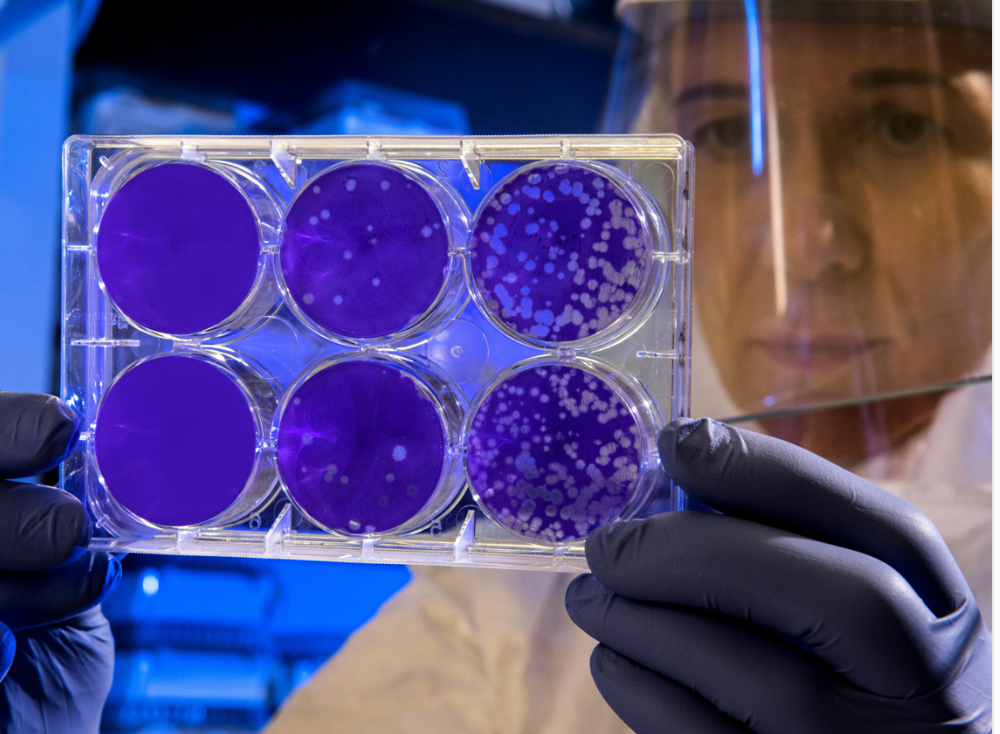
Οι Επιστήμονες κρούουν το κώδωνα κινδύνου για θανατηφόρο παράσιτο που σαρώνει την Ευρώπη

Οι επιστήμονες έχουν σημάνει κόκκινο συναγερμό για την αύξηση ενός θανατηφόρου παρασίτου που είναι ικανό να προκαλέσει θανατηφόρα ηπατική ανεπάρκεια εάν μεταδοθεί στον άνθρωπο. Το συγκεκριμένο παράσιτο, με το πέρασμα των χρόνων αυξάνεται ολοένα και περισσότερο σε παγκόσμιο επίπεδο
Η ταινία της αλεπούς (Echinococcus multilocularis) ζει κυρίως σε άγρια ζώα όπως οι αλεπούδες. Εάν οι άνθρωποι έρθουν σε επαφή με τα αυγά της ταινίας μέσω των περιττωμάτων των μολυσμένων ζώων, τότε μπορεί να εξαπλωθεί πολύ εύκολα. Μόλις εισέλθει στον οργανισμό, το θανατηφόρο παράσιτο μπορεί να πολλαπλασιαστεί στο ήπαρ, προκαλώντας ηπατική ανεπάρκεια και ακόμη και θάνατο.
Μια ομάδα εμπειρογνωμόνων από την Ελβετία συνιστά προσοχή μετά την τριπλασιασμό των κρουσμάτων της νόσου. Αρχικά περιορισμένη στην Ευρώπη, την Κίνα, την Ιαπωνία και τη Σιβηρία, η νόσος εξαπλώνεται πλέον σε περιοχές του Καναδά και σε μέρη των ΗΠΑ.
Σύμφωνα με στοιχεία του Πανεπιστημιακού Νοσοκομείου της Ζυρίχης, το 1993 υπήρχαν περίπου δύο κρούσματα, αλλά ο αριθμός αυτός έχει πλέον αυξηθεί σε 22 το 2022. Σύμφωνα με το CDC, τα άτομα που διατρέχουν υψηλό κίνδυνο περιλαμβάνουν «κυνηγούς, κτηνιάτρους ή άλλα άτομα που έρχονται σε επαφή με άγριες αλεπούδες ή κογιότ, τα κόπρανα τους ή κατοικίδια σκυλιά και γάτες που έχουν την ευκαιρία να φάνε άγρια τρωκτικά μολυσμένα με AE».
Οι επιστήμονες προειδοποιούν: Δύο ώρες στην οθόνη «καίει» τον εγκέφαλο των παιδιών
Οι παρασιτικοί όγκοι που ξεκινούν στο ήπαρ μπορούν να εξαπλωθούν στους πνεύμονες και σε άλλα όργανα. Μερικά από τα συμπτώματα μπορεί να περιλαμβάνουν κοιλιακό άλγος, ίκτερο, απώλεια βάρους και αδυναμία. Η ομοσπονδιακή υπηρεσία συνιστά επίσης να κρατάτε τα κατοικίδια ζώα μακριά από άγρια ζώα και τα περιττώματά τους, διατηρώντας παράλληλα ένα καλό επίπεδο υγιεινής.

Το 2021, ένας άνδρας που παρουσίαζε στομαχικές διαταραχές υποβλήθηκε σε αφαίρεση μιας ταινίας μήκους 18 μέτρων – η μακρύτερη που έχει καταγραφεί στην Ταϊλάνδη τα τελευταία 50 χρόνια. Ο 67χρονος ασθενής, που κατάγεται από την επαρχία Nong Khai, ανέφερε ότι αντιμετώπιζε «μετεωρισμό» από τις αρχές Μαρτίου. Ζήτησε ιατρική βοήθεια σε νοσοκομείο, όπου του ελήφθη δείγμα κοπράνων για εξέταση.
Πως τα φαινομενικά αθώα κλιματιστικά μπορούν να μας οδηγήσουν μέχρι και στο θάνατο
Τα αποτελέσματα των εξετάσεων αποκάλυψαν την παρουσία 28 μολυσματικών προνυμφών, οι οποίες, σύμφωνα με τους γιατρούς, προέρχονταν από μολυσμένο και ατελώς μαγειρεμένο βόειο κρέας.
Αφού χορηγήθηκε φαρμακευτική αγωγή στον ασθενή, το τεράστιο παράσιτο βγήκε από τον πρωκτό του την επόμενη μέρα, στις 20 Μαρτίου. Βίντεο που τραβήχτηκε στο Κέντρο Έρευνας Παρασιτικών Νοσημάτων δείχνει δύο έκπληκτους γιατρούς να ρίχνουν νερό σε ένα τεράστιο τμήμα της ταινίας.

Στη συνέχεια, χρησιμοποίησαν μια λαβίδα για να ξετυλίξουν το παράσιτο και να το τοποθετήσουν σε ένα κόκκινο πλαστικό χαλάκι. Η ταινία είχε μήκος λίγο πάνω από 18 μέτρα (59 πόδια), καθιστώντας την τη μακρύτερη ταινία που έχει παρατηρηθεί στην Ταϊλάνδη τα τελευταία 50 χρόνια.
Ένας εκπρόσωπος του Κέντρου Έρευνας Παρασιτικών Νοσημάτων δήλωσε: «Μια ταινία Taenia saginata βοοειδών μήκους άνω των 18 μέτρων αφαιρέθηκε από έναν ασθενή του οποίου το δείγμα στάλθηκε στο κέντρο. Του χορηγήθηκε φάρμακο για την αποπαρασίτωση πριν τον ύπνο και το πρωί αυτή η μακριά ταινία βγήκε από τον πρωκτό του. Ήταν πολύ μεγάλη και μας πήρε αρκετή ώρα να την απλώσουμε στο έδαφος». Ο άνδρας έλαβε φαρμακευτική αγωγή και του συνιστάται να αλλάξει τις διατροφικές του συνήθειες.